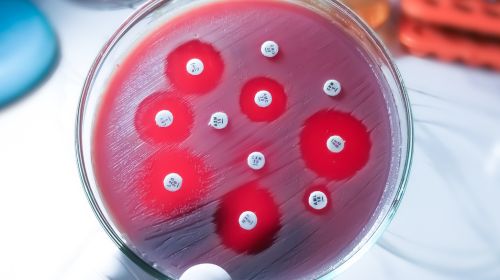

AseBio Te cuenta
Biofármacos
Bioga Comunica
Biomarcadores
Biotecnología
Células madre
Calidad
Caso Práctico
CMO (fabricación a terceros)
Conociendo a...
Consultoría
Cultivos y mantenimiento celular
Defensa biológica
Diagnóstico in vitro
Diagnóstico por imagen
Dispositivos médicos
Drug Delivery
Drug Development
Ensayos clínicos (CRO)
Equipos de laboratorio
Equipos de proceso
Equipos desechables
Eventos
Farmacovigilancia
Filtración
Financiación
Fondos de capital riesgo
Formación
Grata Rerum Novitas
Hemoderivados
I+D
Industria 4.0
Ingenierías e instalaciones
Inteligencia artificial
Laboratorios farmacéuticos tradicionales en proceso de diversificación
Laboratorios tanto Físico/Químicos como de Biología Molecular
Logística
Materias primas y material de acondicionado (líneas celulares, reactivos...)
Negocios & Mercado
Patentes / Legal
Preclínica
Screening
Suministradores de vestuario
Suministros de laboratorio
Terapia celular
Terapia génica
Terapia tisular y biomateriales
Terav innovación española en Terapias Avanzadas
Transformación digital
Trasplantes
Tratamiento de aguas
Vacunas
Varios
Bioga Comunica
TERAV, innovación española en Terapias Avanzadas
Últimos nombramientos
29/01/2026 /
 La Comisión Europea ha aprobado la extensión de la indicación de la vacuna recombinante con adyuvante de GSK frente al virus respiratorio sincitial (VRS), denominada Arexvy, para su... Leer más
La Comisión Europea ha aprobado la extensión de la indicación de la vacuna recombinante con adyuvante de GSK frente al virus respiratorio sincitial (VRS), denominada Arexvy, para su... Leer más
La Comisión Europea amplía la indicación de la vacuna de GSK frente al VRS a adultos a partir de 18 años
 La Comisión Europea ha aprobado la extensión de la indicación de la vacuna recombinante con adyuvante de GSK frente al virus respiratorio sincitial (VRS), denominada Arexvy, para su... Leer más
La Comisión Europea ha aprobado la extensión de la indicación de la vacuna recombinante con adyuvante de GSK frente al virus respiratorio sincitial (VRS), denominada Arexvy, para su... Leer más
29/01/2026 /
 La Asociación Española de Medicamentos Biosimilares, BioSim, ha reforzado su plataforma de divulgación con el lanzamiento de la sección “Biosimilares en cifras –... Leer más
La Asociación Española de Medicamentos Biosimilares, BioSim, ha reforzado su plataforma de divulgación con el lanzamiento de la sección “Biosimilares en cifras –... Leer más
BioSim lanza un observatorio internacional para comparar la adopción de biosimilares en Europa
 La Asociación Española de Medicamentos Biosimilares, BioSim, ha reforzado su plataforma de divulgación con el lanzamiento de la sección “Biosimilares en cifras –... Leer más
La Asociación Española de Medicamentos Biosimilares, BioSim, ha reforzado su plataforma de divulgación con el lanzamiento de la sección “Biosimilares en cifras –... Leer más
28/01/2026 /
 La Fundación Instituto Roche, a través de su Observatorio de Tendencias en la Medicina del Futuro, ha publicado el Informe Anticipando: Estrategias Antimicrobianas en la Medicina del Futuro.... Leer más
La Fundación Instituto Roche, a través de su Observatorio de Tendencias en la Medicina del Futuro, ha publicado el Informe Anticipando: Estrategias Antimicrobianas en la Medicina del Futuro.... Leer más
La Fundación Instituto Roche presenta un informe sobre estrategias antimicrobianas en la medicina del futuro
La Fundación Instituto Roche, a través de su Observatorio de Tendencias en la Medicina del Futuro, ha publicado el Informe Anticipando: Estrategias Antimicrobianas en la Medicina del Futuro.... Leer más
La Fundación Instituto Roche, a través de su Observatorio de Tendencias en la Medicina del Futuro, ha publicado el Informe Anticipando: Estrategias Antimicrobianas en la Medicina del Futuro.... Leer más
28/01/2026 /
 La entidad de certificación IMQ Ibérica ha anunciado la apertura de una nueva edición de su programa de formación online centrado en Ensayos de Seguridad Eléctrica y... Leer más
La entidad de certificación IMQ Ibérica ha anunciado la apertura de una nueva edición de su programa de formación online centrado en Ensayos de Seguridad Eléctrica y... Leer más
IMQ Ibérica impartirá una formación especializada en seguridad eléctrica y EMC para equipos electromédicos
 La entidad de certificación IMQ Ibérica ha anunciado la apertura de una nueva edición de su programa de formación online centrado en Ensayos de Seguridad Eléctrica y... Leer más
La entidad de certificación IMQ Ibérica ha anunciado la apertura de una nueva edición de su programa de formación online centrado en Ensayos de Seguridad Eléctrica y... Leer más
26/01/2026 /
 La plataforma BioLynx ha presentado un nuevo programa de capacitación diseñado para orientar a profesionales del sector biotecnológico y farmacéutico en su desarrollo de carrera.... Leer más
La plataforma BioLynx ha presentado un nuevo programa de capacitación diseñado para orientar a profesionales del sector biotecnológico y farmacéutico en su desarrollo de carrera.... Leer más
BioLynx lanza un programa de mentoría con doce directivos de primer nivel del sector salud
 La plataforma BioLynx ha presentado un nuevo programa de capacitación diseñado para orientar a profesionales del sector biotecnológico y farmacéutico en su desarrollo de carrera.... Leer más
La plataforma BioLynx ha presentado un nuevo programa de capacitación diseñado para orientar a profesionales del sector biotecnológico y farmacéutico en su desarrollo de carrera.... Leer más
26/01/2026 /
 El Instituto de Investigación Sanitaria (IIS) Biogipuzkoa y Farmaindustria han celebrado una nueva edición del programa divulgativo "Acercando la ciencia a las escuelas". La jornada,... Leer más
El Instituto de Investigación Sanitaria (IIS) Biogipuzkoa y Farmaindustria han celebrado una nueva edición del programa divulgativo "Acercando la ciencia a las escuelas". La jornada,... Leer más
Biogipuzkoa y Farmaindustria promueven la investigación biomédica entre estudiantes de secundaria
 El Instituto de Investigación Sanitaria (IIS) Biogipuzkoa y Farmaindustria han celebrado una nueva edición del programa divulgativo "Acercando la ciencia a las escuelas". La jornada,... Leer más
El Instituto de Investigación Sanitaria (IIS) Biogipuzkoa y Farmaindustria han celebrado una nueva edición del programa divulgativo "Acercando la ciencia a las escuelas". La jornada,... Leer más
26/01/2026 /
 El pasado 21 de enero, la sede del Instituto Superior de Derecho y Economía (ISDE Law & Business School) en Madrid acogió la ceremonia de entrega del XIII Premio Nacional de Biotecnología.... Leer más
El pasado 21 de enero, la sede del Instituto Superior de Derecho y Economía (ISDE Law & Business School) en Madrid acogió la ceremonia de entrega del XIII Premio Nacional de Biotecnología.... Leer más
Fernando Peláez recibe el XIII Premio Nacional de Biotecnología en el ISDE Madrid
 El pasado 21 de enero, la sede del Instituto Superior de Derecho y Economía (ISDE Law & Business School) en Madrid acogió la ceremonia de entrega del XIII Premio Nacional de Biotecnología.... Leer más
El pasado 21 de enero, la sede del Instituto Superior de Derecho y Economía (ISDE Law & Business School) en Madrid acogió la ceremonia de entrega del XIII Premio Nacional de Biotecnología.... Leer más
21/01/2026 /
/
194 visitas
 Un estudio liderado por la doctora Marta Navarrete, del Centro de Neurociencias Cajal-CSIC, y publicado en la revista Nature Communications, ha demostrado que los problemas de memoria y aprendizaje derivados... Leer más
Un estudio liderado por la doctora Marta Navarrete, del Centro de Neurociencias Cajal-CSIC, y publicado en la revista Nature Communications, ha demostrado que los problemas de memoria y aprendizaje derivados... Leer más
Los astrocitos, clave en los déficits de memoria inducidos por el cannabis durante la adolescencia
 Un estudio liderado por la doctora Marta Navarrete, del Centro de Neurociencias Cajal-CSIC, y publicado en la revista Nature Communications, ha demostrado que los problemas de memoria y aprendizaje derivados... Leer más
Un estudio liderado por la doctora Marta Navarrete, del Centro de Neurociencias Cajal-CSIC, y publicado en la revista Nature Communications, ha demostrado que los problemas de memoria y aprendizaje derivados... Leer más
20/01/2026 /
/
203 visitas
 El portal especializado Escrapalia ha anunciado la apertura de una subasta pública online para la adquisición de una plataforma tecnológica integral diseñada para optimizar... Leer más
El portal especializado Escrapalia ha anunciado la apertura de una subasta pública online para la adquisición de una plataforma tecnológica integral diseñada para optimizar... Leer más
Subasta pública de una plataforma integral de IA para la optimización de ensayos clínicos oncológicos
 El portal especializado Escrapalia ha anunciado la apertura de una subasta pública online para la adquisición de una plataforma tecnológica integral diseñada para optimizar... Leer más
El portal especializado Escrapalia ha anunciado la apertura de una subasta pública online para la adquisición de una plataforma tecnológica integral diseñada para optimizar... Leer más
19/01/2026 /
 Un equipo del Instituto de Biomedicina de Valencia (IBV-CSIC) ha diseñado un modelo celular basado en cultivos de astrocitos que permite reproducir los mecanismos de la enfermedad de Lafora, una... Leer más
Un equipo del Instituto de Biomedicina de Valencia (IBV-CSIC) ha diseñado un modelo celular basado en cultivos de astrocitos que permite reproducir los mecanismos de la enfermedad de Lafora, una... Leer más
El IBV-CSIC desarrolla un modelo celular in vitro para acelerar la investigación de la enfermedad de Lafora
 Un equipo del Instituto de Biomedicina de Valencia (IBV-CSIC) ha diseñado un modelo celular basado en cultivos de astrocitos que permite reproducir los mecanismos de la enfermedad de Lafora, una... Leer más
Un equipo del Instituto de Biomedicina de Valencia (IBV-CSIC) ha diseñado un modelo celular basado en cultivos de astrocitos que permite reproducir los mecanismos de la enfermedad de Lafora, una... Leer más
19/01/2026 /
/
127 visitas
 La compañía 3PBIOVIAN, especializada en el desarrollo de procesos y fabricación de proteínas recombinantes y terapias avanzadas (CDMO), ha anunciado la obtención de la... Leer más
La compañía 3PBIOVIAN, especializada en el desarrollo de procesos y fabricación de proteínas recombinantes y terapias avanzadas (CDMO), ha anunciado la obtención de la... Leer más
3PBIOVIAN obtiene la certificación CIR francesa para sus sedes de España y Finlandia
 La compañía 3PBIOVIAN, especializada en el desarrollo de procesos y fabricación de proteínas recombinantes y terapias avanzadas (CDMO), ha anunciado la obtención de la... Leer más
La compañía 3PBIOVIAN, especializada en el desarrollo de procesos y fabricación de proteínas recombinantes y terapias avanzadas (CDMO), ha anunciado la obtención de la... Leer más
16/01/2026 /
/
137 visitas
 Según los últimos datos del Registro Español de Estudios Clínicos (REEC), coordinado por la Aemps, España autorizó 962 ensayos clínicos con medicamentos... Leer más
Según los últimos datos del Registro Español de Estudios Clínicos (REEC), coordinado por la Aemps, España autorizó 962 ensayos clínicos con medicamentos... Leer más
Liderazgo europeo en investigación clínica: España encabeza el registro CTIS por delante de Francia y Alemania
 Según los últimos datos del Registro Español de Estudios Clínicos (REEC), coordinado por la Aemps, España autorizó 962 ensayos clínicos con medicamentos... Leer más
Según los últimos datos del Registro Español de Estudios Clínicos (REEC), coordinado por la Aemps, España autorizó 962 ensayos clínicos con medicamentos... Leer más
15/01/2026 /
/
116 visitas
 La biotecnológica gallega SunRock Biopharma encabeza el proyecto CATIB, una iniciativa seleccionada por la Agencia Estatal de Investigación en su convocatoria 2024 de colaboración... Leer más
La biotecnológica gallega SunRock Biopharma encabeza el proyecto CATIB, una iniciativa seleccionada por la Agencia Estatal de Investigación en su convocatoria 2024 de colaboración... Leer más
SunRock Biopharma lidera el proyecto CATIB con una inversión de 1,84 millones de euros en inmunología
 La biotecnológica gallega SunRock Biopharma encabeza el proyecto CATIB, una iniciativa seleccionada por la Agencia Estatal de Investigación en su convocatoria 2024 de colaboración... Leer más
La biotecnológica gallega SunRock Biopharma encabeza el proyecto CATIB, una iniciativa seleccionada por la Agencia Estatal de Investigación en su convocatoria 2024 de colaboración... Leer más
14/01/2026 /
/
192 visitas
 En un movimiento sin precedentes para el sector salud, NVIDIA y Eli Lilly and Company han anunciado la creación de un laboratorio conjunto de innovación en el área de la Bahía... Leer más
En un movimiento sin precedentes para el sector salud, NVIDIA y Eli Lilly and Company han anunciado la creación de un laboratorio conjunto de innovación en el área de la Bahía... Leer más
NVIDIA y Eli Lilly crean un gigante de la innovación: 1.000 millones de dólares para transformar la industria con IA
 En un movimiento sin precedentes para el sector salud, NVIDIA y Eli Lilly and Company han anunciado la creación de un laboratorio conjunto de innovación en el área de la Bahía... Leer más
En un movimiento sin precedentes para el sector salud, NVIDIA y Eli Lilly and Company han anunciado la creación de un laboratorio conjunto de innovación en el área de la Bahía... Leer más
14/01/2026 /
/
138 visitas
 La Comisión Europea ha presentado una propuesta para la futura Ley de Biotecnología, integrada en un paquete de medidas que incluye la revisión de reglamentos de productos sanitarios... Leer más
La Comisión Europea ha presentado una propuesta para la futura Ley de Biotecnología, integrada en un paquete de medidas que incluye la revisión de reglamentos de productos sanitarios... Leer más
Efpia y Farmaindustria analizan el impacto de la nueva normativa en la soberanía estratégica y la I+D europea
 La Comisión Europea ha presentado una propuesta para la futura Ley de Biotecnología, integrada en un paquete de medidas que incluye la revisión de reglamentos de productos sanitarios... Leer más
La Comisión Europea ha presentado una propuesta para la futura Ley de Biotecnología, integrada en un paquete de medidas que incluye la revisión de reglamentos de productos sanitarios... Leer más
13/01/2026 /
/
109 visitas
 La Asociación Española de Bioempresas (AseBio) ha anunciado el lanzamiento de una nueva edición de los Premios AseBio de Comunicación y Divulgación de la Biotecnología.... Leer más
La Asociación Española de Bioempresas (AseBio) ha anunciado el lanzamiento de una nueva edición de los Premios AseBio de Comunicación y Divulgación de la Biotecnología.... Leer más
AseBio convoca una nueva edición de sus premios para impulsar la divulgación biotecnológica
 La Asociación Española de Bioempresas (AseBio) ha anunciado el lanzamiento de una nueva edición de los Premios AseBio de Comunicación y Divulgación de la Biotecnología.... Leer más
La Asociación Española de Bioempresas (AseBio) ha anunciado el lanzamiento de una nueva edición de los Premios AseBio de Comunicación y Divulgación de la Biotecnología.... Leer más
12/01/2026 /
/
121 visitas
 Un estudio internacional liderado por el Instituto de Biología Molecular de Barcelona (IBMB-CSIC) y la Universidad La Trobe (Australia) ha redefinido lo que sabíamos sobre la apoptosis y... Leer más
Un estudio internacional liderado por el Instituto de Biología Molecular de Barcelona (IBMB-CSIC) y la Universidad La Trobe (Australia) ha redefinido lo que sabíamos sobre la apoptosis y... Leer más
El descubrimiento de la "masticación celular": un cambio de paradigma en la eliminación de células muertas
 Un estudio internacional liderado por el Instituto de Biología Molecular de Barcelona (IBMB-CSIC) y la Universidad La Trobe (Australia) ha redefinido lo que sabíamos sobre la apoptosis y... Leer más
Un estudio internacional liderado por el Instituto de Biología Molecular de Barcelona (IBMB-CSIC) y la Universidad La Trobe (Australia) ha redefinido lo que sabíamos sobre la apoptosis y... Leer más
12/01/2026 /
/
145 visitas
 Un consorcio internacional liderado por el Instituto de Biomedicina de Valencia (IBV-CSIC) y el National Reference Center for Campylobacters and Helicobacters (Francia) ha marcado un antes y un después... Leer más
Un consorcio internacional liderado por el Instituto de Biomedicina de Valencia (IBV-CSIC) y el National Reference Center for Campylobacters and Helicobacters (Francia) ha marcado un antes y un después... Leer más
Medicina de precisión contra el cáncer gástrico: el fin del fracaso terapéutico en H. pylori
 Un consorcio internacional liderado por el Instituto de Biomedicina de Valencia (IBV-CSIC) y el National Reference Center for Campylobacters and Helicobacters (Francia) ha marcado un antes y un después... Leer más
Un consorcio internacional liderado por el Instituto de Biomedicina de Valencia (IBV-CSIC) y el National Reference Center for Campylobacters and Helicobacters (Francia) ha marcado un antes y un después... Leer más
12/01/2026 /
/
248 visitas
 La biotecnológica mAbxience, participada mayoritariamente por Fresenius Kabi, ha alcanzado un hito histórico tras recibir la aprobación de la FDA para sus solicitudes de licencia biológica... Leer más
La biotecnológica mAbxience, participada mayoritariamente por Fresenius Kabi, ha alcanzado un hito histórico tras recibir la aprobación de la FDA para sus solicitudes de licencia biológica... Leer más
Boncresa™ y Oziltus™: Los nuevos activos de mAbxience y Amneal para el mercado oncológico y de osteoporosis
 La biotecnológica mAbxience, participada mayoritariamente por Fresenius Kabi, ha alcanzado un hito histórico tras recibir la aprobación de la FDA para sus solicitudes de licencia biológica... Leer más
La biotecnológica mAbxience, participada mayoritariamente por Fresenius Kabi, ha alcanzado un hito histórico tras recibir la aprobación de la FDA para sus solicitudes de licencia biológica... Leer más
12/01/2026 /
/
139 visitas
 El Dr. Íñigo Martincorena, líder de grupo en el Wellcome Sanger Institute, ha sido distinguido con la decimoquinta edición del Premio Nacional de Investigación en Cáncer... Leer más
El Dr. Íñigo Martincorena, líder de grupo en el Wellcome Sanger Institute, ha sido distinguido con la decimoquinta edición del Premio Nacional de Investigación en Cáncer... Leer más
El Dr. Íñigo Martincorena, galardonado con el XV Premio Nacional de Investigación en Cáncer 2025
 El Dr. Íñigo Martincorena, líder de grupo en el Wellcome Sanger Institute, ha sido distinguido con la decimoquinta edición del Premio Nacional de Investigación en Cáncer... Leer más
El Dr. Íñigo Martincorena, líder de grupo en el Wellcome Sanger Institute, ha sido distinguido con la decimoquinta edición del Premio Nacional de Investigación en Cáncer... Leer más
19/12/2025 /
/
198 visitas
 Cristina Nadal, directora ejecutiva de Government Affairs de MSD España, ha sido elegida presidenta de la Asociación Española de Bioempresas (AseBio) durante la Asamblea General Ordinaria... Leer más
Cristina Nadal, directora ejecutiva de Government Affairs de MSD España, ha sido elegida presidenta de la Asociación Española de Bioempresas (AseBio) durante la Asamblea General Ordinaria... Leer más
Cristina Nadal, nueva presidenta de AseBio
 Cristina Nadal, directora ejecutiva de Government Affairs de MSD España, ha sido elegida presidenta de la Asociación Española de Bioempresas (AseBio) durante la Asamblea General Ordinaria... Leer más
Cristina Nadal, directora ejecutiva de Government Affairs de MSD España, ha sido elegida presidenta de la Asociación Española de Bioempresas (AseBio) durante la Asamblea General Ordinaria... Leer más
19/12/2025 /
/
221 visitas
 Nueve startups han participado en la cuarta edición de CaTaPull UP, el programa de escalado deep tech del Parque Científico de Madrid (PCM), una iniciativa que impulsa el emprendimiento científico-tecnológico... Leer más
Nueve startups han participado en la cuarta edición de CaTaPull UP, el programa de escalado deep tech del Parque Científico de Madrid (PCM), una iniciativa que impulsa el emprendimiento científico-tecnológico... Leer más
Nueve startups deep tech culminan la cuarta edición de CaTaPull UP, el programa de escalado del Parque Científico de Madrid
 Nueve startups han participado en la cuarta edición de CaTaPull UP, el programa de escalado deep tech del Parque Científico de Madrid (PCM), una iniciativa que impulsa el emprendimiento científico-tecnológico... Leer más
Nueve startups han participado en la cuarta edición de CaTaPull UP, el programa de escalado deep tech del Parque Científico de Madrid (PCM), una iniciativa que impulsa el emprendimiento científico-tecnológico... Leer más
19/12/2025 /
/
124 visitas
 Con la llegada de la Navidad y el cierre de un año lleno de retos y avances, desde Farmabiotec queremos trasladar nuestro más sincero agradecimiento a todos los profesionales, investigadores,... Leer más
Con la llegada de la Navidad y el cierre de un año lleno de retos y avances, desde Farmabiotec queremos trasladar nuestro más sincero agradecimiento a todos los profesionales, investigadores,... Leer más
Farmabiotec les desea unas felices fiestas y un próspero 2026 para la biotecnología
 Con la llegada de la Navidad y el cierre de un año lleno de retos y avances, desde Farmabiotec queremos trasladar nuestro más sincero agradecimiento a todos los profesionales, investigadores,... Leer más
Con la llegada de la Navidad y el cierre de un año lleno de retos y avances, desde Farmabiotec queremos trasladar nuestro más sincero agradecimiento a todos los profesionales, investigadores,... Leer más
17/12/2025 /
/
278 visitas
 La Agencia Española de Medicamentos y Productos Sanitarios (AEMPS) ha autorizado el primer ensayo clínico en fase I de la industria farmacéutica acogido al nuevo procedimiento de evaluación... Leer más
La Agencia Española de Medicamentos y Productos Sanitarios (AEMPS) ha autorizado el primer ensayo clínico en fase I de la industria farmacéutica acogido al nuevo procedimiento de evaluación... Leer más
La AEMPS autoriza el primer ensayo oncológico fast track de la industria bajo las nuevas guías aceleradas
 La Agencia Española de Medicamentos y Productos Sanitarios (AEMPS) ha autorizado el primer ensayo clínico en fase I de la industria farmacéutica acogido al nuevo procedimiento de evaluación... Leer más
La Agencia Española de Medicamentos y Productos Sanitarios (AEMPS) ha autorizado el primer ensayo clínico en fase I de la industria farmacéutica acogido al nuevo procedimiento de evaluación... Leer más
16/12/2025 /
/
149 visitas
 El Instituto de Investigación Sanitaria Fundación Jiménez Díaz (IIS-FJD) y Farmaindustria celebraron ayer en Madrid una nueva edición del programa Acercando la ciencia... Leer más
El Instituto de Investigación Sanitaria Fundación Jiménez Díaz (IIS-FJD) y Farmaindustria celebraron ayer en Madrid una nueva edición del programa Acercando la ciencia... Leer más
Farmaindustria y el IIS-Fundación Jiménez Díaz acercan la investigación biomédica a más de 250 estudiantes en Madrid
 El Instituto de Investigación Sanitaria Fundación Jiménez Díaz (IIS-FJD) y Farmaindustria celebraron ayer en Madrid una nueva edición del programa Acercando la ciencia... Leer más
El Instituto de Investigación Sanitaria Fundación Jiménez Díaz (IIS-FJD) y Farmaindustria celebraron ayer en Madrid una nueva edición del programa Acercando la ciencia... Leer más
Utilizamos cookies propias y de terceros para elaborar información estadística y mostrarte publicidad personalizada a través del análisis de tu navegación, conforme a nuestra
Política de cookies.
Si continúas navegando, aceptas su uso.
Más información
Si continúas navegando, aceptas su uso.
Más información
Política de privacidad | Cookies | Aviso legal | Información adicional| miembros de CEDRO









































